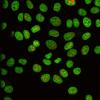

您的位置:首页 > Tags >核仁
人细胞核与荧光标记的染色质(绿色)和核仁(红色)。一组科学家们发现,细胞的健康状况部分地维持,部分地,他们的核仁的两种运

巨噬细胞的核仁(绿色)在细菌感染时缩小(左:未感染的巨噬细胞,右:细菌感染巨噬细胞)。© Max Planck老龄化生物

耶鲁实验室发现了可以减少核仁数量的蛋白质,从而使细胞的蛋白质工厂化。这一发现对癌症研究具有重要意义。(图片来源:巴塞尔加

长寿命的果蝇(右)具有较小的核仁,而不是其较短的亲属(左)。mpi f。衰老的生物学 V TikuMax Planc
图文推荐

2022-01-08 11:58:03

2022-01-08 10:58:03

2022-01-08 09:58:03

2022-01-08 08:58:03

2022-01-07 19:58:00

2022-01-07 18:58:00
热点排行
精彩文章

2022-01-08 10:58:04

2022-01-08 09:58:05

2022-01-08 08:58:04

2022-01-07 19:58:02

2022-01-07 18:58:02

2022-01-07 17:58:02
热门推荐
